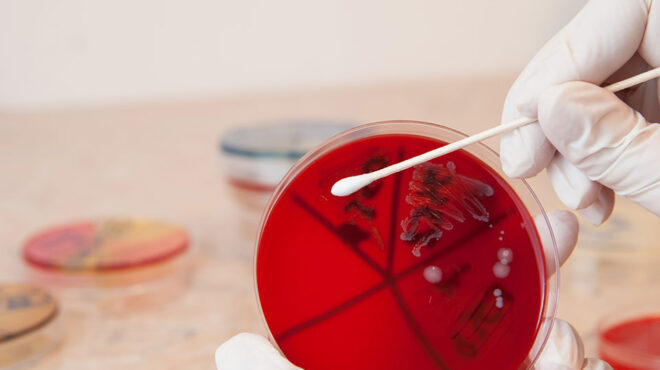
στρεπτόκοκκος-αλλάζει-η-επιδημιολογ-562468387

«Δεν έχουμε σαφή εικόνα γιατί από πέρυσι οι στρεπτοκοκκικές λοιμώξεις είναι πιο συχνές. Είναι κάτι που παρατηρήθηκε αρχικά στο Ηνωμένο Βασίλειο όπου υπάρχει πολύ καλή επιδημιολογική επιτήρηση. Εκεί είδαν ότι υπάρχει αύξηση και στις απλές λοιμώξεις του στρεπτόκοκκου και στις διεισδυτικές» λέει στην «Κ» ο Αναπληρωτής Καθηγητής Υγιεινής και Επιδημιολογίας, Γκίκας Μαγιορκίνης για το μικρόβιο που φέτος μάς έχει απασχολήσει πολύ και στην Ελλάδα, ενώ πριν από δύο ημέρες «ανέβασε» στη χώρα μας τον αριθμό των παιδιών που έχασαν τη ζωή τους στα 6.
Σημειώνεται ότι ο στρεπτόκοκκος της ομάδας Α (GAS) είναι ένα κοινό βακτήριο. Πολλοί από εμάς φέρουμε στον λαιμό και στο δέρμα μας το βακτήριο χωρίς να εμφανίζουμε συμπτώματα λοίμωξης (φορεία του παθογόνου). Ωστόσο, το συγκεκριμένο παθογόνο μπορεί να προκαλέσει σε ορισμένες περιπτώσεις λοίμωξη, ήπια ή και πιο σοβαρή. Οι σοβαρές λοιμώξεις που συνδέονται με το GAS προέρχονται από τον διεισδυτικό στρεπτόκοκκο της ομάδας Α (iGAS).
Στις πιο συνηθισμένες εκφράσεις του ο στρεπτόκοκκος «χτυπά» με αμυγδαλίτιδα ή φαρυγγίτιδα. «Αυτό δεν σημαίνει πως κάθε φαρυγγίτιδα οφείλεται σε στρεπτόκοκκο. Μια στις τρεις φαρυγγίτιδες έχουν προκύψει από το εν λόγω μικρόβιο» σημειώνει ο κ. Μαγιορκίνης προσθέτοντας ότι μια πιθανή εξήγηση για την αύξηση των λοιμώξεων από στρεπτόκοκκο, είναι πως έχει πέσει η συλλογική ανοσία απέναντι στο μικρόβιο.
Στην ερώτηση γιατί κάποιοι προσβάλλονται από τα επιθετικά-διεισδυτικά στελέχη, ο κ. Μαγιορκίνης λέει πως πιθανόν υπάρχει κάποιο γενετικό υπόβαθρο ή/και ευαισθησία στα συγκεκριμένα άτομα. «Σε πολλές από τις περιπτώσεις των διεισδυτικών στελεχών, ό,τι και να κάνεις, το παιχνίδι χάνεται. Η σηψαιμία μέσα σε 48 ώρες που εμφανίστηκε στο παιδί στην Ημαθία, είναι πολύ σπάνια περίπτωση».
Ο καθηγητής σημειώνει πάντως πως οι έξι θάνατοι παιδιών στην Ελλάδα είναι ένα σημαντικό νούμερο για τη χώρα μας, παρόμοιο με αυτό του Ηνωμένου Βασιλείου όπου σύμφωνα με τον κ. Μαγιορκίνη τον τελευταίο χρόνο, καταγράφονται επτά θάνατοι ανά 10.000.000 πληθυσμού.
Ο ίδιος τονίζει ακόμα πως τα στρεπ τεστ για τη διάγνωση του στρεπτόκοκκου δεν είναι πανάκεια, μιας και όπως λέει, η ευαισθησία τους είναι χαμηλή- γύρω στο 50%. Όπως τονίζει: «Αν ο γιατρός έχει υποψία στρεπτόκοκκου θα χορηγήσει αντιβίωση και χωρίς το τεστ. Το τεστ βοηθάει να σιγουρευτούμε ότι πρόκειται για το εν λόγω μικρόβιο».
Αύξηση 30% στα κρούσματα στρεπτόκοκκου βλέπουν φέτος οι παιδίατροι
Ο Κώστας Νταλούκας, πρόεδρος των Ελευθεροεπαγγελματιών Παιδιάτρων Αττικής λέει με τη σειρά του στην «Κ» πως η εμπειρία των παιδιάτρων από τη φετινή χρονιά, στα ιατρεία τους, δείχνει αύξηση των κρουσμάτων της τάξης του 30% σε σχέση με την προ πανδημική περίοδο. Η εν λόγω αύξηση αφορά στην πιο κοινή μορφή εκδήλωσης του στρεπτόκοκκου, τη φαρυγγίτιδα.
Όσο για την προσβολή από τα επικίνδυνα-διεισδυτικά στελέχη, αυτό είναι σε μεγάλο βαθμό και θέμα συγκυρίας. Όμως: «η ηλικία του παιδιού, η κατάσταση του ανοσοποιητικού του συστήματος, το αν έχει ή όχι υποκείμενα νοσήματα, παίζουν ρόλο στο πως θα εξελιχθεί η λοίμωξη», τονίζει ο παιδίατρος, προσθέτοντας πως η έγκαιρη διάγνωση είναι απαραίτητη για όποια μορφή του στρεπτόκοκκου κι αν μιλάμε.
Κατά τον ίδιο, τα τελευταία χρόνια, αρκετοί γονείς έχουν αρχίσει να υιοθετούν μια πιο χαλαρή συμπεριφορά στο θέμα των επισκέψεων στον/στην παιδίατρο. «Πολλοί πιστεύουν ότι με την τηλεφωνική διάγνωση αντιμετωπίζονται όλα τα προβλήματα. Η φετινή έξαρση των ιών δείχνει ότι αυτό δεν είναι σωστός τρόπος», τονίζει ο κ. Νταλούκας εξηγώντας και ποιο είναι το πιο ανησυχητικό σύμπτωμα του στρεπτόκοκκου: ο πυρετός.
«Πρέπει να ανησυχεί τους γονείς από την πρώτη ημέρα και να τους κάνει να επικοινωνούν άμεσα με τον παιδίατρο τους. Είναι σύμπτωμα που δεν πρέπει να υποτιμάται. Όπως και ένας έντονος σωματικός πόνος. Και φυσικά το εξάνθημα. Τα στρεπ τεστ λοιπόν από τους γονείς δεν έχουν ιδιαίτερο νόημα, τόσο γιατί πολλές φορές δεν λαμβάνεται σωστά το δείγμα, όσο και γιατί είναι απαραίτητη η συνεκτίμηση του γιατρού».
Ο έμπειρος παιδίατρος σημειώνει πάντως πως οι έξι θάνατοι των παιδιών στην Ελλάδα δείχνουν μια αύξηση των κρουσμάτων της διεισδυτικής λοίμωξης του στρεπτόκοκκου και στη χώρα μας. «Ίσως έχει αλλάξει η επιδημιολογική εικόνα του μικροβίου, με αποτέλεσμα να κάνουν πιο συχνά την εμφάνισή τους τα επιθετικά στελέχη», εξηγεί ο κ. Νταλούκας προσθέτοντας πως σε χώρες του εξωτερικού όπου γίνεται επιδημιολογική επιτήρηση υπάρξει αύξηση της διεισδυτικής λοίμωξης σε ποσοστό 1% με 3%, ενώ «η Ελλάδα δείχνει να βρίσκεται σε αυτό το 1%».
Τα lockdown που έριξαν την ανοσία και η αλλαγή της εποχικότητας ιών και μικροβίων
Για το ζήτημα μίλησε στην «Κ» και η Ιωάννα Παυλοπούλου, Καθηγήτρια Παιδιατρικής του ΕΚΠΑ. Η ίδια αποδίδει επίσης την αύξηση των κρουσμάτων στη μείωση της ανοσίας απέναντι σε διάφορα μικρόβια, ανάμεσα τους και στο συνηθισμένο μικρόβιο του στρεπτόκοκκου, εξαιτίας των περιοριστικών μέτρων της πανδημίας, τα οποία κράτησαν τον κόσμο για πολύ καιρό στο σπίτι.
«Η αλήθεια είναι ότι την μεταπανδημική περίοδο, σημειώνεται μια γενικευμένη έξαρση των ιών οι οποίοι δρουν υποβοηθητικά στις βαρύτερες μικροβιακές λοιμώξεις», σημειώνει η κ. Παυλόπουλου. Η ίδια υπογραμμίζει πως εκτός από τη μείωση της ανοσίας, έχει αλλάξει και η εποχικότητα ιών και μικροβίων- μέχρι πρότινος, ο στρεπτόκοκκος εμφανιζόταν χειμώνα και άνοιξη. Τώρα, δίνει κρούσματα και το καλοκαίρι.
«Το είδαμε και με τον RSV και με τη γρίπη αυτό. Η εποχικότητα μετά το τέλος των lockdown άλλαξε και πια απαιτείται επαγρύπνηση απέναντι σε αυτή τη συμπεριφορά», προσθέτει η καθηγήτρια.
Τέλος, η κ. Παυλοπούλου τονίζει την ανάγκη για άμεση επικοινωνία με τον/την παιδίατρο επί συμπτωμάτων: «Αν το παιδί έχει πονόλαιμο, εξάνθημα, πονάει η κοιλιά του, έντονη αδιαθεσία κ.τ.λ, τότε πρέπει ο γονιός να επικοινωνήσει με τον γιατρό. Αυτός αποφασίζει αν θα γίνει η οποιαδήποτε εξέταση. Ο στρεπτόκοκκος χρειάζεται έγκαιρη αξιολόγηση, αλλά όχι πανικό».
Ακολουθήστε το kathimerini.gr στο Google News και μάθετε πρώτοι όλες τις ειδήσεις
Δείτε όλες τις τελευταίες Ειδήσεις από την Ελλάδα και τον Κόσμο, στο kathimerini.gr